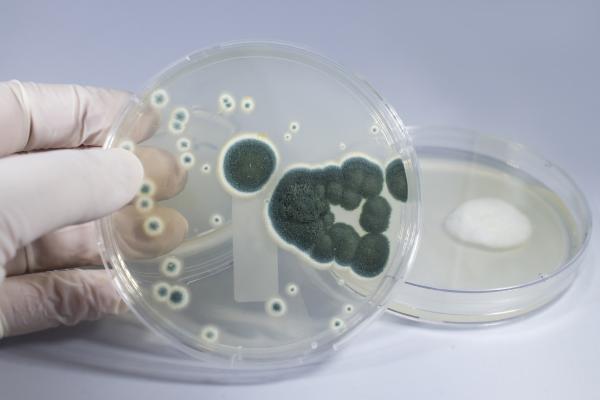
Relaciones interespecíficas: qué son y ejemplos - Amensalismo
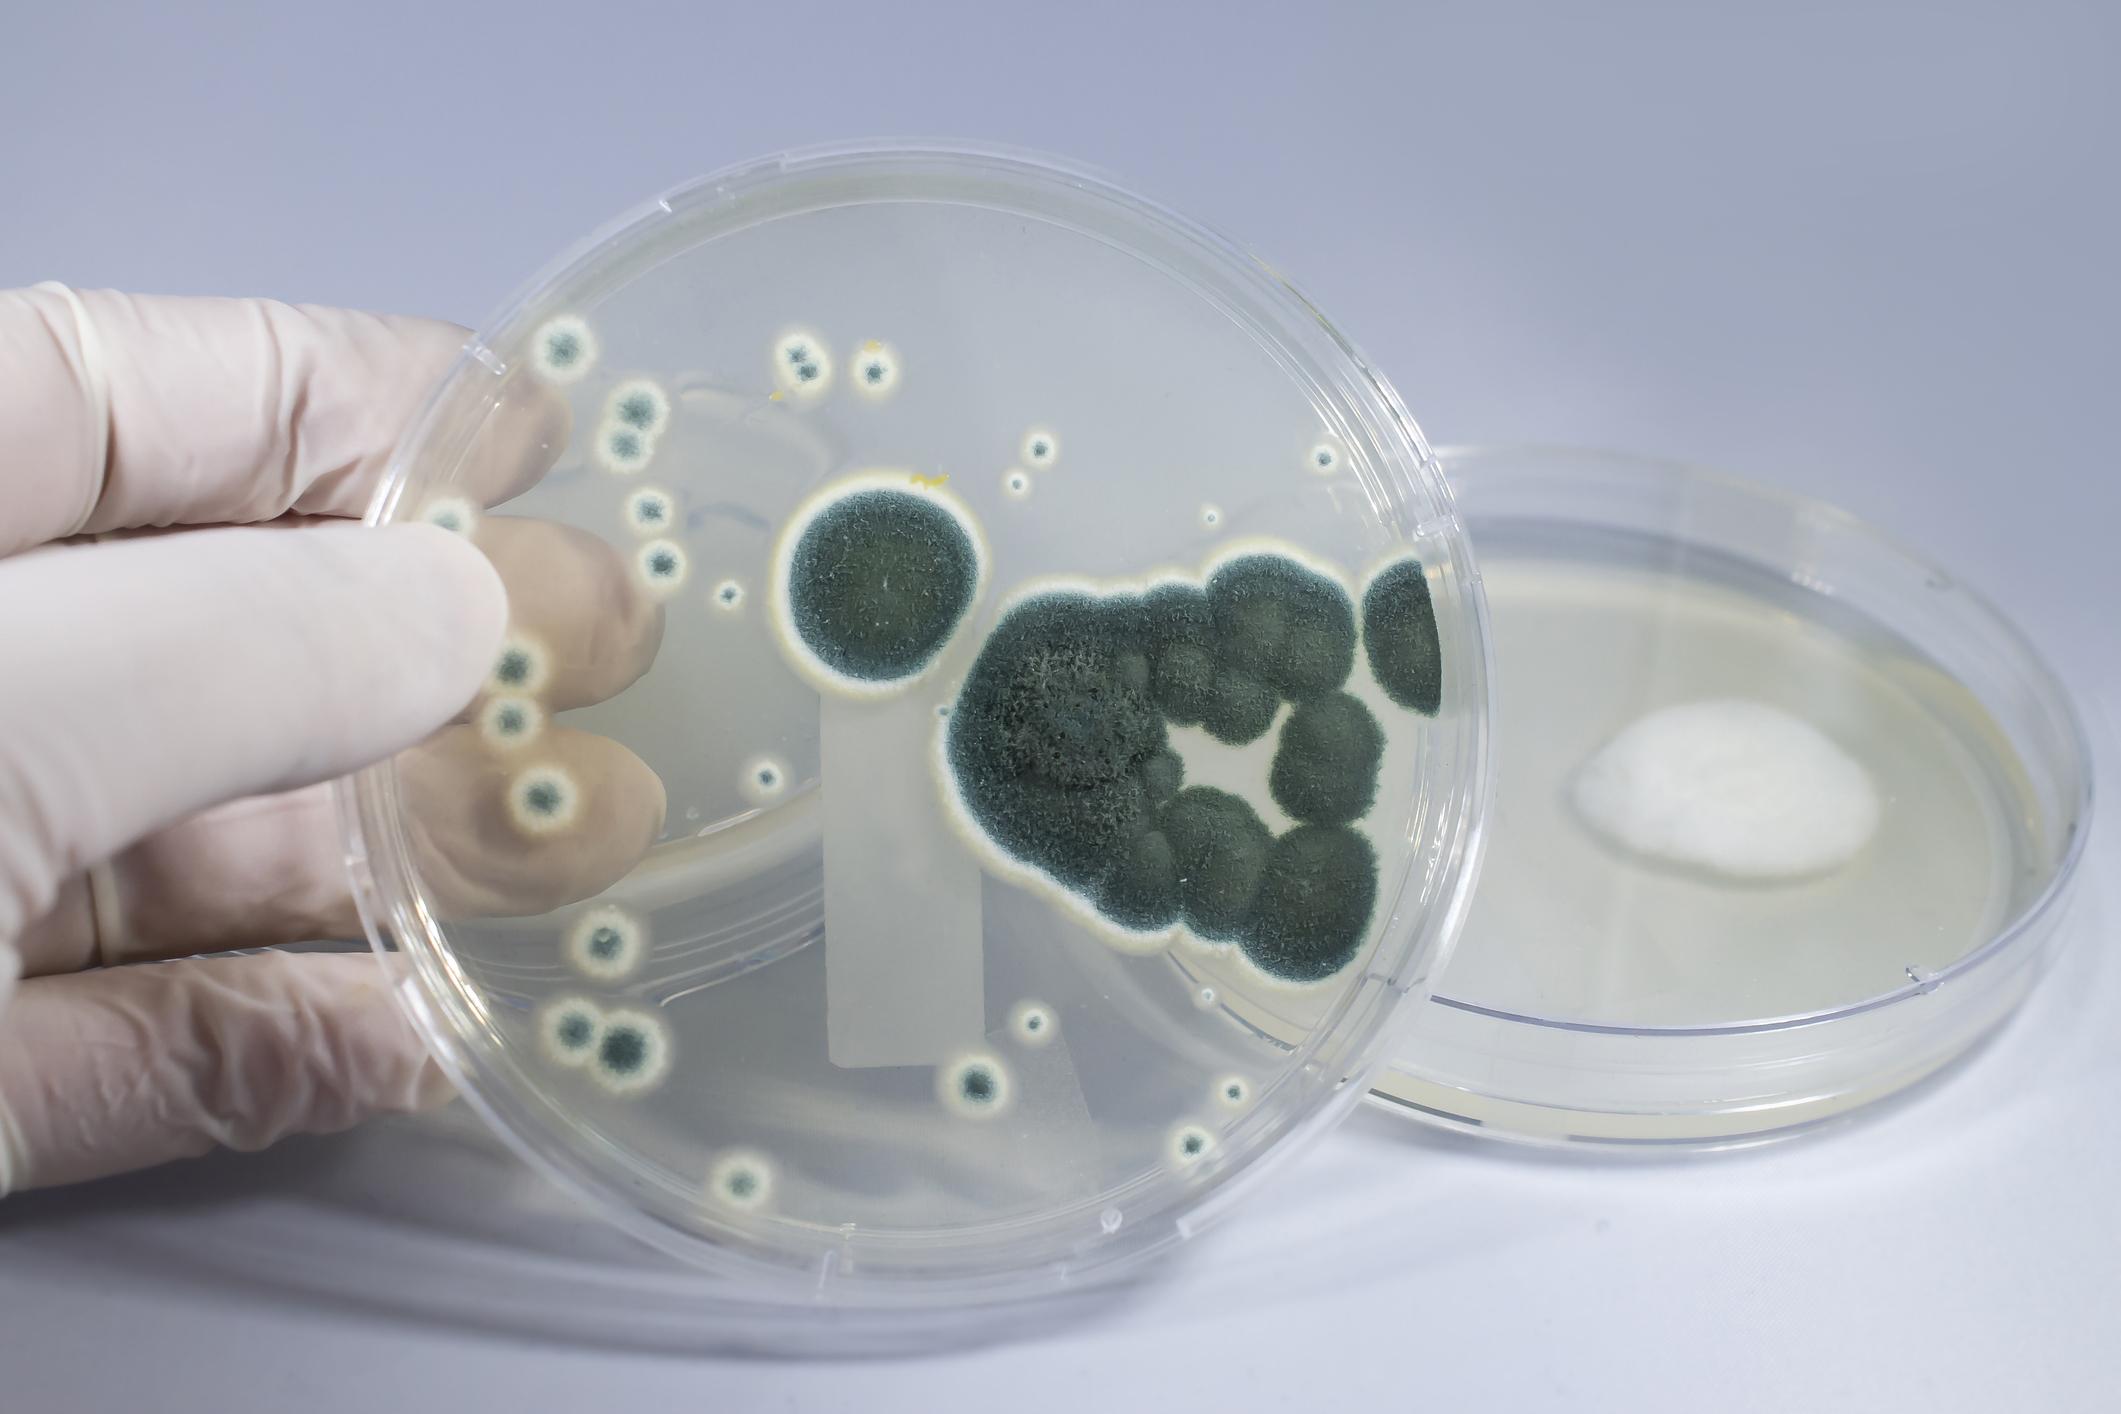

Relaciones interespecíficas: qué son y ejemplos


Muchos de los animales, plantas y microorganismos, entre otros, prefieren formar alianzas entre ellos para sobrevivir. Otros simplemente cumplen su papel en el nicho ecológico y viven en el ecosistema conviviendo con otras especies. Sea cual sea la forma en la que se desenvuelvan los individuos de una comunidad, probablemente estemos hablando de algún tipo de relación interespecífica. Si quieres conocer qué son las relaciones interespecíficas y ejemplos, te invitamos a leer este artículo de BIOenciclopedia donde aprenderás sobre ello.
Qué son las relaciones interespecíficas y sus tipos
Las relaciones interespecíficas son todos los tipos de interacciones que se puedan dar entre dos o más individuos que pertenecen a diferentes especies. Estas relaciones se dan dentro de un ecosistema, y, en general, se llevan a cabo para complacer alguna necesidad territorial, alimenticia, reproductiva, por refugio, o alguna otra que enfrente el individuo.
Por otro lado, existen dos tipos de relaciones interespecíficas, estos son:
- Relaciones interespecíficas positivas: mutualismo, comensalismo, simbiosis e inquilinismo.
- Relaciones interespecíficas negativas: parasitismo, depredación, amensalismo y competencia.
A continuación, explicamos cada relación que conforma los dos tipos de relaciones interespecíficas.
Mutualismo
El mutualismo es una relación interespecífica positiva (+/+), donde ambas especies se benefician y cooperan para mantener su ciclo de vida. La relación que se da entre las dos especies tiene algún grado de colaboración y tolerancia entre ellas. Las relaciones de mutualismo pueden ser:
- Recurso – recurso: cuando las especies intercambian recursos mutuamente. Por ejemplo: la relación entre los rizobios y las plantas leguminosas encaja con este tipo de relación, ya que las los rizobios proporcionan el nitrógeno, producido por ellos, a las leguminosas, y ellas proporcionan carbohidratos para que puedan realizar sus actividades.
- Servicio – recurso natural: un ejemplo es la polinización, en este caso la abeja realiza un servicio, dispersando el polen de la planta, a cambio del néctar.
- Servicio – servicio: ambas especies realizan un servicio beneficioso para el otro. Por ejemplo, el pez payaso y la anémona de mar se protegen mutuamente.

Comensalismo
Es una relación interespecífica positiva (+/O), la cual solo beneficia a uno, pero no afecta al otro individuo involucrado. En este tipo de relación específica se suele usar dos términos para referirse a cada individuo:
- Comensal: es el que resulta beneficiado con los restos de comida, generalmente, dejado por el huésped.
- Huésped: es el individuo que realiza con normalidad sus actividades, y que beneficia al comensal.
Estos son algunos ejemplos de especies que usan el comensalismo:
- El león (huésped) y las hienas de África (comensal).
- Las esponjas de mar (huésped) y las pulgas de mar (comensal).
- Las anemonas marinas (huésped) y el pez payaso (comensal).
- El alce (huésped) y el coyote (comensal).

Simbiosis
Es una relación interespecífica positiva (+/+), la cual se desarrolla mediante la cooperación de ambas especies. La mayoría de veces se lleva una relación tan estrecha que, prácticamente, dependen una a la otra. Estos son un par de ejemplos de simbiosis:
- Un hongo y un alga. Cooperan para formar líquenes.
- La microbiota humana y la persona. Algunos microorganismos presentes en nosotros contribuyen en la degradación de los alimentos, por lo que son esenciales.

Inquilinismo
El inquilinismo es una relación interespecífica positiva (+/0), en el que un individuo se beneficia y el otro no se perjudica, ni beneficia. Este tipo de relación se basa en que, el beneficiario busca refugio en algún resto de otro individuo, o incluso suelen establecerse en el cuerpo de este. Estos son algunos ejemplos de inquilinismo:
- Las ardillas, generalmente, buscan refugio en los troncos de los árboles.
- Los balanos (Balanus sp.) habitan en las conchas de bivalvos, o dentro de la piel de ballenas.

Parasitismo
El parasitismo es una relación interespecífica negativa (+/-), en la cual solo un individuo se beneficia, y además causa daños al otro organismo. Estos son ejemplos de parasitismo:
- Los endoparásitos (bacterias, nematodos, protozoarios) infectan los intestinos del ser humano, provocándole serios daños a su salud.
- Los ectoparásitos, como las pulgas y garrapatas se fijan a la piel de nuestras mascotas para succionarles la sangre.

Depredación
La depredación es una relación interespecífica negativa (+/-), donde un individuo provoca la muerte de otro a causa de su propio beneficio. Cuando hablamos de este tipo de relación, solemos referirnos a los individuos de la siguiente forma:
- Depredador: Es el que causa la muerte de otro individuo.
- Presa: Es el que se encuentra en riesgo constante.
Estos son algunos ejemplos de depredación:
- El lobo depreda al alce.
- El tigre se alimenta de jabalíes.
- El oso atrapa los salmones para comérselos.

Amensalismo
El amensalismo es una relación interespecífica negativa (O/-), donde un individuo perjudica a otro, sin embargo este no experimenta ningún tipo de beneficio, ya que solo está realizando sus actividades normales. Estos son un par de ejemplos de amensalismo:
- Las bacterias se ven perjudicas a causa de la sustancia que produce el hongo Penicillium.
- Algunos tipos de algas expulsan sustancias toxicas que perjudica a diferentes especies marinas.
Competencia
La competencia es una relación interespecífica negativa (-/-), este tipo de relación es perjudicial para ambos individuos, debido a las peleas que se pueda dar entre ellos. Las riñas podrían ser a causa del territorio o recursos alimenticios. Estos son algunos ejemplos de competencia:
- El jabalí y el elefante podrían enfrentarse para acceder a un pozo con agua.
- Las hienas y leones compiten por las presas de su territorio.
- Los chacales y buitres se pelean por la carroña que dejan los grandes depredadores.
Ahora que conoces mejor las relaciones interespecíficas o relaciones entre especies, te recomendamos leer sobre Las funciones vitales de los seres vivos: qué son y cuáles son.

Si deseas leer más artículos parecidos a Relaciones interespecíficas: qué son y ejemplos, te recomendamos que entres en nuestra categoría de Biología.
- Pérez, Y. (2022). Ecología de comunidades y conservación. Universidad Autónoma del Estado de Hidalgo. https://repository.uaeh.edu.mx/bitstream/bitstream/handle/123456789/20121/relaciones-interespecificas.pdf?sequence=1&isAllowed=y
- Instituto Nacional General José Miguel Carrera. (2019). Interacciones (3): Interacciones Biológicas. Departamento de Biología. https://institutonacional.cl/wp-content/uploads/2019/11/1-Biolog%C3%ADa-Gui%CC%81a-3-Interacciones-Biolo%CC%81gicas.pdf